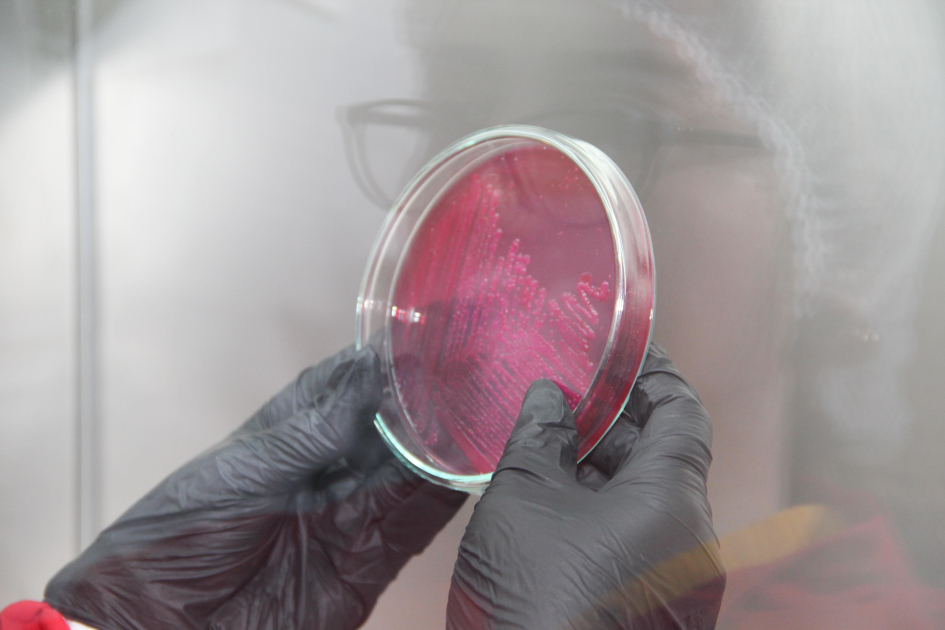
Ölkəmizdə ilk dəfə “Biotəhlükəsizlik və biomühafizə” fənni tədris olunacaq

Ölkəmizdə ilk dəfə “Biotəhlükəsizlik və biomühafizə” fənni tədris olunacaq

Ölkəmizdə ilk dəfə Azərbaycan Dövlət Aqrar Universitetinin (ADAU) Baytarlıq təbabəti fakültəsində “Biotəhlükəsizlik və biomühafizə” adlı fənn yaradılıb.
Universitetdən “Azərbaycan müəllimi”nə bildirilib ki, bu istiqamətdə ADAU-da artıq cari ildən I kurs tələbələrinə tədris olunacaq “Biotəhlükəsizlik və biomühafizə” adlı fənn üzrə metodiki göstəriş hazırlanıb.
Biotəhlükəsizlik insanları, heyvanları və ətraf mühiti xəstəliklərin törətdikləri fəsadlardan qorumaq və onlara nəzarət etmək üçün ən effektiv tədbirlər sistemidir. Biotəhlükəsizlik hər bir baytar həkimin və fermerin iş prinsiplərindən biri və qarşıya qoyduğu əsas vəzifəsi olmalıdır. Həmçinin biotəhlükəsizlik yoluxucu maddələrlə işləyən şəxsin, laboratoriyanın, ictimaiyyət və ətraf mühitin yoluxucu maddələrə yoluxma riskini minimuma endirmək və ya qarşısını almaq üçün təhlükəsizlik və mühafizə tədbirlərinin tətbiqidir.